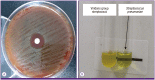

Diagnosis of pneumococcal pneumonia: current pitfalls and the way forward
- PMID: 24475349
- PMCID: PMC3902818
- DOI: 10.3947/ic.2013.45.4.351
Diagnosis of pneumococcal pneumonia: current pitfalls and the way forward
Abstract
Streptococcus pneumoniae is the most common cause of community-acquired pneumonia. However, it can also asymptomatically colonize the upper respiratory tract. Because of the need to distinguish between S. pneumoniae that is simply colonizing the upper respiratory tract and S. pneumoniae that is causing pneumonia, accurate diagnosis of pneumococcal pneumonia is a challenging issue that still needs to be solved. Sputum Gram stains and culture are the first diagnostic step for identifying pneumococcal pneumonia and provide information on antibiotic susceptibility. However, these conventional methods are relatively slow and insensitive and show limited specificity. In the past decade, new diagnostic tools have been developed, particularly antigen (teichoic acid and capsular polysaccharides) and nucleic acid (ply, lytA, and Spn9802) detection assays. Use of the pneumococcal antigen detection methods along with biomarkers (C-reactive protein and procalcitonin) may enhance the specificity of diagnosis for pneumococcal pneumonia. This article provides an overview of current methods of diagnosing pneumococcal pneumonia and discusses new and future test methods that may provide the way forward for improving its diagnosis.
Keywords: Diagnosis; Pneumococcal pneumonia; Polymerase chain reaction; Streptococcus pneumoniae.
Figures

References
-
- Marrie TJ, Huang JQ. Epidemiology of community-acquired pneumonia in Edmonton, Alberta: an emergency department-based study. Can Respir J. 2005;12:139–142. - PubMed
-
- Fine MJ, Smith MA, Carson CA, Mutha SS, Sankey SS, Weissfeld LA, Kapoor WN. Prognosis and outcomes of patients with community-acquired pneumonia. A meta-analysis. JAMA. 1996;275:134–141. - PubMed
-
- Musher DM, Alexandraki I, Graviss EA, Yanbeiy N, Eid A, Inderias LA, Phan HM, Solomon E. Bacteremic and nonbacteremic pneumococcal pneumonia. A prospective study. Medicine (Baltimore) 2000;79:210–221. - PubMed
Publication types
LinkOut - more resources
Full Text Sources
Other Literature Sources
Medical
Research Materials
Miscellaneous